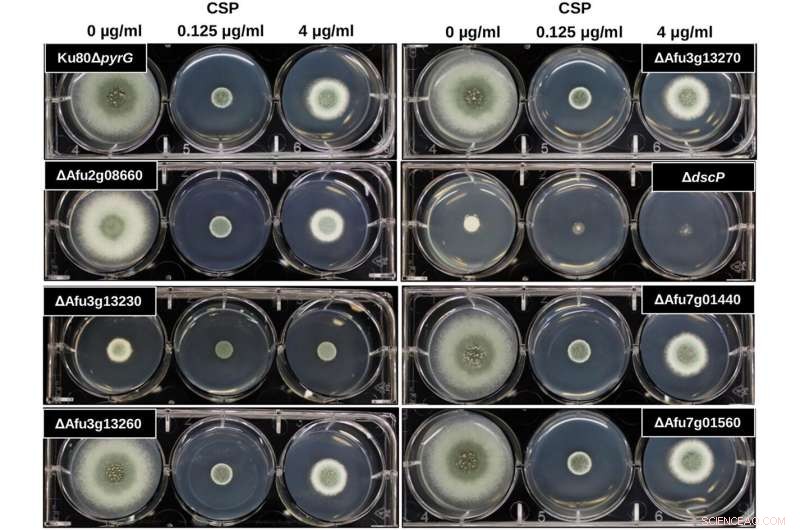
Genomic Insights Drive New Strategies to Combat Deadly Fungal Infections

Screen for presence of the caspofungin paradoxical effect among mutant strains. Ten thousand conidia were inoculated into GMM containing 0, 0.125, or 4 μg/mL of caspofungin. The culture plates were incubated at 37°C for 72 h. Credit: Microbiology Spectrum (2022). DOI: 10.1128/spectrum.00519-22
A research team led by a University of Massachusetts Amherst scientist has made a significant genetic discovery that sheds light on the use of the drug caspofungin to treat a deadly fungal infection, Aspergillus fumigatus, which kills some 100,000 severely immunocompromised people each year.
Typically, healthy people inhale about 50 to 100 spores of A. fumigatus every day when outdoors. "Our body does a great job of identifying them and destroying them," says UMass Amherst associate professor of food science John Gibbons, whose microbial genomics lab studies the fungus.
But in people with compromised immune systems from cancer treatment, organ transplants, HIV, COVID-19 and other conditions, A. fumigatus can cause "a really nasty infection, invasive pulmonary aspergillosis, with a 50% mortality rate," Gibbons says. "And there's a limited way to treat these infections."
To complicate matters, when given in high concentrations as a treatment for an A. fumigatus infection, the anti-fungal drug sometimes creates a "caspofungin paradoxical effect" [CPE], which increases the fungal growth rather than eradicating it.
In research published in the journal Microbiology Spectrum, senior author Gibbons, Shu Zhao, a former graduate student in the Gibbons lab, and colleagues describe a first important step in the effort to understand when and why treatment with caspofungin could be more harmful than beneficial. The team, including scientists from Vanderbilt University, the University of Tennessee Science Health Center and the University of São Paolo in Brazil, completed the first genomic and molecular identification of two genes that contribute to the paradoxical effect in A. fumigatus.
"This is one of the first studies to apply genome-wide association (GWA) analysis to identify genes involved in an Aspergillus fumigatus phenotype," the paper states.
The team sequenced the genome of 67 clinical samples, about half of which had CPE, spotting genetic differences between the groups and then using GWA, a statistical method, to determine how these genetic variants are associated with growth patterns at high concentrations of caspofungin. "We identified a few candidate genes that we thought might contribute to this paradoxical effect," Gibbons says.
The scientists then used the genetic engineering technology, CRISPR, to delete those candidate genes from the genome, creating gene-deletion mutants and enabling the researchers to determine that two of the genes were involved in the paradoxical effect.
"It looks like there are many genes and many genetic variants that contribute to this phenotype," Gibbons says. "We aren't done yet. One idea is that we could potentially generate new drug targets if we find the full collection of genes. We don't understand the mechanisms yet."
Ultimately the team hopes they can use DNA sequencing to understand the genetic basis of different phenotypes in general and to predict for clinical benefits if a patient sample of A. fumigatus has a genotype that is associated with the paradoxical effect.
"That would be an important tool that could really improve treatment," Gibbons says. + Explore further